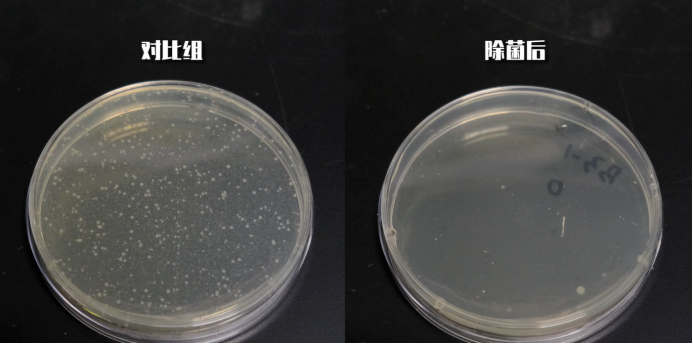
测试后我们可以看到,莱克吉米b302pro的杀菌效果值得肯定, 大肠杆菌

杀菌效果

杀菌效果对比图
图片尺寸802x423
普通的3cr13mo不锈钢和经不同热处理后的3cr13mocu不锈钢的杀菌效果图
图片尺寸1779x1185
洗衣服你关注过杀菌效果吗
图片尺寸1080x1439
xdh01 消毒收纳盒 健康的杀菌方式_效果
图片尺寸1000x1498
uvcled紫外线杀菌效果该怎么评估3535uvc灯珠275nm
图片尺寸674x657
强酸性电解水对蔬菜杀菌效果
图片尺寸1080x838
测试后我们可以看到,莱克吉米b302pro的杀菌效果值得肯定, 大肠杆菌
图片尺寸693x344
农极客新品上市:药搭配微生物菌剂,降低病害抗性,增强杀菌效果.
图片尺寸670x1288
杀菌效果对比
图片尺寸1080x608
9% 的杀菌效果,值得信赖~总之,哪里觉得脏,就喷一喷.
图片尺寸1126x616
puretta智能马桶杀菌器杀菌效果999
图片尺寸800x800
家居装修实测杀菌效果太好是什么体验
图片尺寸1080x1920
大棚土传病,重茬问题的解决方法及土壤消毒杀菌新技术
图片尺寸640x640
因素依赖过高,且所需时间较长,要暴晒六个小时才能达到一定杀菌效果
图片尺寸660x557
全新好推出零度杀菌口罩干纸巾杀菌系列黑科技深交所关注函连番质疑
图片尺寸600x289
更好杀菌效果1
图片尺寸750x480
在杀灭有害菌的同时,保留了牛奶中更多活性营养物质,真正从杀菌效果
图片尺寸660x615
教你做出完美的抑菌圈!抑菌圈法是衡量杀菌防霉剂效果 - 抖音
图片尺寸9600x7200
应用在水性涂料上的杀菌剂如何来看杀菌效果这个视频告诉您
图片尺寸6000x4000
超声波技术对食品杀菌效果及其与巴氏杀菌法的差异探究
图片尺寸824x523